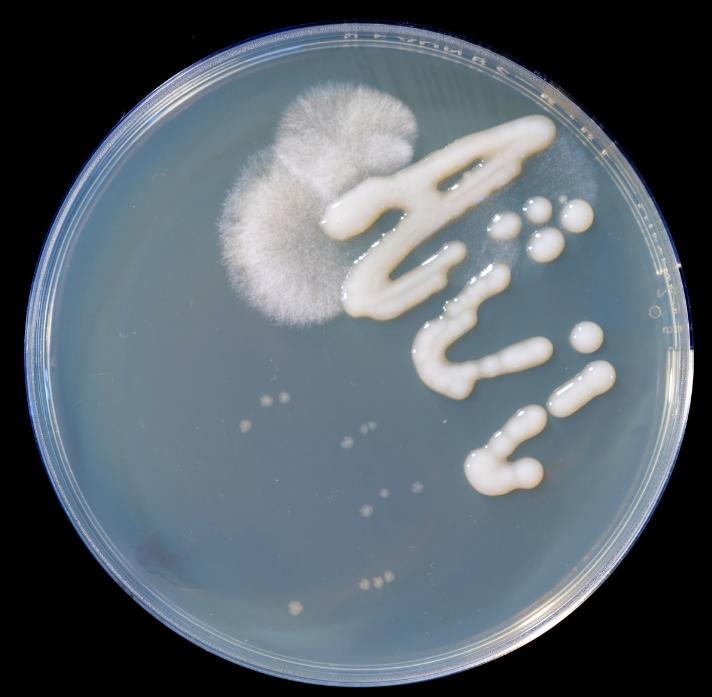
治灰指甲要验血吗,医院检查灰指甲挂号什么科

一、 初识患者
小刘几个前发现自己的脚趾甲表面变得不光滑,渐渐地还出现了很多白斑,最初他没有在意,后来他发现出现这些白斑不仅没有消退,而且在不断扩张,损害的面积越来越大并且受损的趾甲也越来越多,趾甲边缘慢慢变脆。他感到很不安,觉得自己得了灰指甲,于是前来医院就诊。接诊后我仔细看检查了小刘的趾甲,可以看到多个趾甲受损,患甲甲板浑浊,颜色呈现灰白,呈现虫蚀状,甲脆性增加,用镊子夹取容易脆裂。

我将患甲用刀片刮下一部分碎屑送去检验科进行真菌镜检以及真菌培养。过了一会儿小刘拿着化验单和收费单来到诊室,用有些不满的语气说:“不就是一个小小的灰指甲嘛,怎么要做那么多检查,结果什么都没查出来,还有一个培养检查,要等两周,真是浪费患者的时间和金钱!”我接过小刘的化验单看到真菌镜检的单子上写着:未见可疑真菌。此时我心中有数了。于是安抚道:先别急,甲真菌病的诊断基本是没有问题的,所有这些检查也都是必要的。
那么看似简单的灰指甲,真的需要做一大堆检查吗?而检查结果还要等那么长时间有必要吗?医生的做法是不是折腾病人或者过度诊疗呢?
要解释这几个疑问我需要为大家科普一下以下几个内容:
- 什么是甲真菌病?甲真菌病又称甲癣,俗称灰指甲,是一种发生在人指(趾)甲的一种传染性疾病。它是由真菌感染引起的。传染途径一般为直接接触传染,好发人群一般为糖尿病患者,局部血液循环不良、系统性疾病导致免疫受损、甲外伤或其他甲病患者等,居住环境过于潮湿温暖、个人生活卫生不佳也可诱发
- 什么是真菌镜检?在可疑真菌感染病灶取皮屑、甲屑、病发等标本,经过处理将标本置普通光学显微镜下检查。显微镜下可见真菌菌丝和孢子菌可判断为阳性。
- 什么是真菌培养?从临床标本中培养真菌,培养需要在一定温度下培养2~4周。一般若无真菌生长可报阴性;若发现培养出真菌,可报阳性。之后还可以进行真菌的种类鉴定。

图片来源于网络,非本病例患者检查图
图片用于向大家科普展示真菌镜检显微镜下真菌菌丝形态以及真菌培养培养皿中真菌菌落形态,并非本患者检验图片
由于在标本收集以及制备过程中可能会出现真菌漏掉的情况,因此真菌镜检在临床诊断中偶尔会出现“假阴性”情况,如果临床症状又高度怀疑真菌感染,那么真菌培养就可以再一定程度上弥补直接镜检的不足,提高致病真菌的检出率。因此真菌镜检与培养,不仅为甲真菌病的诊断提供最有力的证据,还是治疗选择用药的参考依据。因此,该两项检查必不可少。
二、治疗过程
经过我的讲解之后,小刘明白了检验的意义,2周后真菌培养结果出来,医院通知患者前来取报告,报告显示真菌培养阳性。这样就确诊了疾病——甲真菌病,接下来就是制定治疗方案了。
由于趾甲(指甲)自身致密的结构可以阻碍外用药的渗入,这就为甲真菌病的治疗带来了较大困难。因此本次治疗选择了口服药为主,外用药为辅的治疗思路。用药前详细询问小刘的疾病史、药物过敏史以及是否有备孕的需求等情况,完善了血常规、肝肾功能检查。
采用伊曲康唑胶囊冲击治疗,连续口服1周、停药3周为一疗程,连续3疗程。药品随餐口服。由于用药过程中可能会有肝损害的几率,因此用药后需要每月监测血常规、肝肾功能
甲的生长是从根部开始长至前端,且手指甲与足趾甲生长的速度是不同的,手指甲的平均生长速度约为每月3.5毫米。用药后不能够将已经被腐蚀掉的趾甲“焕然一新起死复生”而是让新长出来的甲有足够的抗真菌药抵御、抑制真菌,然后新甲全面将旧甲顶掉。结合甲的生长速度,可以看出,手指甲用药后完全好大概需要3个月以上,脚趾甲则需要9个月左右乃至更久一些。向小刘讲清楚用药治疗的特点后安抚小刘对治疗要有耐心。
三、患者治疗中的注意事项
1、需要小刘了解到内服药物治疗甲癣的优点是有效、方便。但其缺点是有一定的不良反应发生率。主要是肝功能损害,因此需要在服药前以及服药过程中查肝功能。由于服药时间长,且并非连续用药,治疗有间隔期,因此患者容易忘记服药而中断治疗。若服药过程中出现厌食、恶心、呕吐、疲劳、腹痛或血尿等症状需要立即停药,并且到医院随访。
2、不能急于求成。伊曲康唑口服后很好的后效应,停药后3~9个月血液中仍然可以测出有效浓度的药物。结合趾甲生长的特点,小刘不可因为用药初期没有明显的患甲变化而过早停药。
四、治疗效果
患者用药后按时到医院复查血常规、肝功能以及肾功能,均未发现药物损害;6个月网络门诊随访未见加重;9个月网络门诊随访双足趾甲呈现正常光泽,未见明显灰白状斑片;目前仍在随访中。

五、患者日常生活中的注意事项
1、要求小刘的指甲剪要用前用后消毒,不与他人混用
2、小刘的擦脚巾、浴巾不与他人混用,定期消毒日晒;袜子不与他人混洗,不与其它衣服混洗,不使用洗衣洗袜子
3、不去修脚、修甲店,以免传染他人
六、医生感悟
甲真菌病,又称甲癣,俗称灰指甲,是很常见的甲病变,很多患者都认识它,本病历中的小刘所用的治疗方法是目前治疗甲癣很常见的、常规的治疗方式,并没有什么新意和创新点。在此我主要是想着重为大家解释在最初接诊小刘时遇到的情况——为什么做化验。因为有很多朋友在自我诊断得了“灰指甲”的时候,认为这种“小毛病”医生却“大动干戈”做化验,是不是“过度诊疗”?是不是“钻进钱眼里”?
因此有必要向大家科普一下,发生在指甲/趾甲上的颜色变化、形状变化、质地变化的疾病并不是只有甲癣,还有其它疾病,比如如下几种:

银屑病甲损害:甲面不规则的点状凹陷,甲远端剥离
银屑病甲损害:甲面不规则的点状凹陷,甲远端剥离

白甲:这三张分别为甲真菌的近端型、远端型以及白甲。从外观上看,十分接近
白甲:这三张分别为甲真菌的近端型、远端型以及白甲。从外观上看,十分接近

图3

图4
甲营养不良:上边的图3甲真菌病浅表型与下边图4的甲营养不良,也很难区分

左图甲癣,右边的甲湿疹
甲湿疹:左图甲癣,右边的甲湿疹临床表现和甲癣类似,但常波及多个甲,且对称分布,往往伴有其他部位的皮肤湿疹。

左图甲癣,右侧的扁平苔藓甲损害
扁平苔藓甲损害:左图甲癣,右侧的扁平苔藓甲损害与甲真菌病初期难以分辨

图6

图7

图8
甲母质瘤:上图图6甲癣,中间图7以及下图图8的2张图示为甲母质瘤,从肉眼上几乎一模一样。
除了上述一些常见的甲损害之外还有许多与甲癣相近、相似的疾病。如果仅仅从甲外观上就诊断,很容易犯经验主义错误。由于甲真菌病治疗疗程长、口服药治疗可能有不良反应,一旦误诊就容易错过最佳治疗时机,乃至引起不好的后果。
上述这些和甲真菌病相似的疾病基本上都可以通过真菌镜检、真菌培养鉴别,有时候采用上述检测方法也难以区分的时候还需要借助甲病理等其它辅助检查来区分。
因此对于灰指甲,做化验,并不是多此一举,而是非常必要。
(文中用于疾病鉴别的甲疾病图片取自李若瑜教授讲座,在此衷心感谢李教授的分享!)
注:普通大众不具备扎实的医学基础,当出现症状或不适感时应尽早到医院就诊,不可以将他人的病例与自己的症状相对应,容易出现“按图索骥”导致误判的情况。科普的目的是为了提高大众对疾病的认识,并不是鼓励大家自诊。#非常病例#